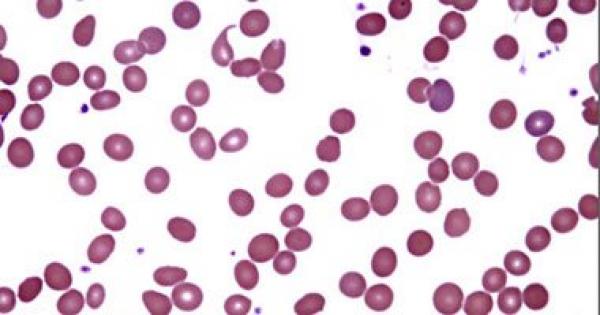
أبرز الأطعمة لزيادة عدد كريات الدم الحمراء لدى مرضى الأنيميا

إسلام إبراهيم
تعتبر كريات الدم الحمراء أحد المكونات بالغة الأهمية بالدم بشكل خاص وجسم الإنسان بشكل عام، حيث تساهم فى نقل الأكسجين إلى أنسجة الجسم، وتساعده على التخلص من ثانى أكسيد الكربون من الدم، وهى تتميز باللون الأحمر نتيجة لاحتوائها على بروتين الهيموجلوبين الذى يحوى الحديد داخله بشكل رئيسى.
وأشار الباحثون إلى أن الحديد يعد من العناصر الضرورية لبناء الهيموجلوبين وبالتالى التخلص من مشكلة نقص كرات الدم الحمراء، ومن أبرز الأطعمة التى تحتوى على عنصر الحديد: الكبدة والكلاوى والفول والعدس والسبانخ واللفت والخوخ والزبيب المجفف وصفار البيض.
وتابع الباحثون أن تناول الأطعمة التى تحتوى على الفوليك اسيد يساهم أيضاً فى زيادة عدد كرات الدم الحمراء لدى الكثير من المرضى، ومن أبرز تلك الأطعمة: الحبوب الكاملة والسبانخ واللفت والفول والبازلاء والمكسرات.
وأضاف الباحثون من خلال التقرير الذى نشر مؤخراً على الموقع الإلكترونى لمستشفى ويسكونسن للأطفال أن رفع مستويات فيتامين ب 12 يساهم أيضاً بشكل كبير فى علاج نقص كرات الدم الحمراء وبالتالى يحد من مرض الأنيميا، ومن أهم الأطعمة: الكبدة والأسماك واللبن ومنتجاته والبيض واللحوم الحمراء، وهو ضرورى لتخليق الحمض النووى وتحفيز إنتاج كريات الدم الحمراء من النخاع العظمى.

_1774476962.webp)




